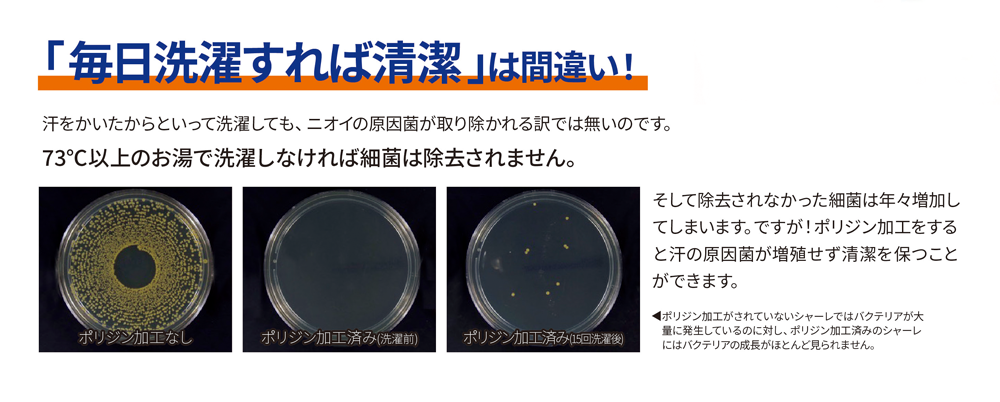
毎日洗濯すれば清潔は間違い

3 レッド
MJ0084 リサイクルストレッチワークブルゾン(ポリジン加工)
動きやすいストレッチ素材を使用した防風性のあるブルゾン。
3 レッド
抗菌
防臭
メーカー価格
8,250円(税込)
販売価格
4,537円(税込)
サイズ
| サイズ | 着丈 | 身頃 | 肩幅 | 袖丈 |
|---|---|---|---|---|
| S | 65 | 50 | 43 | 60.5 |
| M | 67 | 53 | 45.5 | 62 |
| L | 70 | 56 | 48 | 63.5 |
| XL | 73 | 60 | 50.5 | 65 |
| XXL | 76 | 66 | 53.5 | 67 |
商品詳細
注意
メーカーお取り寄せ商品のためこちらの商品は返品不可となります。
サイズ交換・不良商品の交換・商品在庫切れによるキャンセルに関しましてはお受けいたします。
「サイズ交換・キャンセル・返品に関するご案内」をご確認ください。
商品説明
動きやすいストレッチ素材を使用した防風性のあるブルゾン。
ペットボトルを再利用した環境に配慮。抗菌防臭加工を施したワークブルゾンです。
素材:ストレッチタフタ ポリエステル100%(再生ペット50%使用)
仕様:ストッパー付ファスナー/裾幅を調整できるドローコード付

ネーム刺繍を選択できます。おすすめ!
アルファユニのネーム刺繍で、いつものウェアに個性をプラス!豊富な書体とカラーから選んで簡単オーダー。あなただけの特別な一枚を手軽に実現しませんか?
オリジナル加工はカートから購入可能です!
刺繍・プリント加工が出来ます!
この商品は下記の刺繍・プリント加工を追加することが出来ます。
ネーム刺繍
左胸 |
左袖 |
右袖 |
後ろ襟下 |
|
|---|---|---|---|---|
| ネーム刺繍 |
|
|
|
|
その他加工
後ろ裾 |
右袖 |
左袖 |
左胸 |
後ろ襟下 |
|
|---|---|---|---|---|---|
| 刺繍ワッペン |
|
|
|
|
|
| デザイン刺繍 |
|
|
|
|
|
| シルクプリント |
|
|
|
|
|
| DTFプリント |
|
|
|
|
|
| 昇華転写プリントワッペン |
|
|
|
|
|
この商品に似ている商品
特集
チーム・プレゼント・販促用にぴったりのオリジナルネックウォーマー
オリジナル刺繍、プリント入りのネックウォーマーが作れます!野外活動やスポーツチームにも好評のネックウォーマーにオリジナル刺繍やプリントができます。シーン別におすすめのネックウォーマーをご紹介します。【新導入】遠赤外線であったか持続!「ホットレイ糸」遠赤外線を放射する特殊な「ホットレイ糸」を採用。その抜群の保温力で、体の芯からじんわりと温め、寒い冬でも長時間ぬくもりをキープします。さらに、伸縮性にも優れているため、首にしっかりフィットし快適な着け心地を保ちます。スロス(SLOTH)DF2903 ベーシックネックウォーマーメーカー価格 2,145円 (税込)販売価格 1,287円 (税込)カラバリ...
さっと羽織れるパーカー・ブルゾン特集
季節の変わり目に、スクラブの上にさっと羽織れる季節の変わり目の体温調節に欠かせないパーカーやブルゾン。パーカーの中でも医療従事者の方におすすめなのはジップパーカー。スクラブの上からさっと羽織れて脱ぎ着も楽々。ここでは室内で過ごすのに最適なパーカー。野外でもしっかり防寒できるパーカーなど、目的別にアルファユニのおすすめをご紹介します。軽くて薄いパーカー綿パーカー裏起毛パーカーブルゾン着心地重視?防寒対策?パーカーの選び方軽くて薄い、着心地重視の「裏パイル地」裏パイル地は、吸水性と伸縮性が高い裏生地です。表面が毛羽立っておらず着ぶくれしにくいので、スクラブの上などからでもさっと羽織ることができます...
新登場!ukaスクラブに映えるくすみカラー刺繍糸
この特集では、人気ブランド“uka”のスクラブを、くすみカラーとネーム刺繍の魅力とともにご紹介します。上品なくすみカラーが院内にやさしい空気を広げ、着る人をより引き立てます。さらに、同系色の刺繍でさりげなく個性を添えれば、毎日の仕事がもっと特別に。"uka"スクラブの魅力気分が上がるユニフォーム、着たことありますか?毎日身につけるユニフォームだからこそ、もっと「うれしくなる」ものを選んでほしい。そんな想いから生まれたukaスクラブは、上品なくすみカラーと洗練されたシルエットにこだわりました。動きやすく美しいシルエットは、一日を快適にサポートします。ukaスクラブは、着るたびに自分を好きになれる...
救急医療・介護におすすめの医療ウェア特集
これからの季節にぴったり! 寒さ対策におすすめの暖かい医療ウェアスクラブだけでは寒いシーズンになりました。肌寒さによる体の冷えに悩まされる方も多いのではないでしょうか。寒い季節も暖かく快適に過ごすための、おすすめのジャケットやブルゾンなどの医療ウェア・ユニフォームをご紹介します。458オールウェイズインモーションジャケット(レディス)460レディセットゴージャケット(メンズ)9006SCブルゾン(男女兼用)Z1032 ラウンドネックジャケットUZL1201 ジャケット肌寒い季節におすすめの暖かい医療ウェア柔らかい触り心地で、快適なフィット感のストレッチジャケットコイ(Koi)|レディースKOI...
過去注文と同じ加工を商品に入れる場合